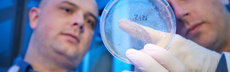
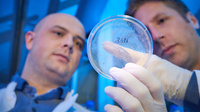

ImmunoSensation
Goto first pageOverview
Beyond the boundariesIn this multimedia project we introduce some of our outstanding group leaders and their innovative research approaches – beyond the boundaries of classical immunology.

Mighty Macrophages
Mighty macrophagesAt the Life and Medical Sciences Institute (LIMES), developmental biologist Elvira Mass and her team are researching the innate immune system. Her research shows: The cells of this system are extremely long-lived - and they play a significant role not only in the immune response. In a current project, Mass and her team are investigating how nanoplastics influence the function of macrophages in our brain.
Birth of microgliaThis process can be followed step by step using induced pluripotent stem cells (iPSCs). The image shows human iPSC-derived pre-macrophages, which will differentiate into microglia, the tissue-resident macrophages of the brain, over time.
Image: Nelli Blank (Mass Lab)
Synaptic pruningMicroglia are very well studied. It's known that they are important for development of blood vessels, but also throughout the early brain development. They regulate neuronal function through synaptic pruning — a process where microglia phagocytose excess neuronal synapses to produce a functional neuronal network.
Cleaning up the brainConfocal imaging makes phagocytosis visible. The image shows a microglia (turquois) of a mouse with phagosomes (green) and pieces of synapses (magenta) that have been phagocytosed. This is only one of the many functions of microglia during development. Also during adulthood, microglia maintain neural network function. Thus, if you disturb the homeostatic function of microglia, you also disturb brain function, which could subsequently lead to neurodegeneration.
Image: Eliana Franco Taveras (Mass lab)
Plastic in our brainIn their “NanoGlia” project, Mass and her team are investigating how nanoplastics influence the function of macrophages in our brains – and what role this might play in the development of neurodegenerative diseases. According to the WWF, we ingest an average of five grams of plastic per week – through food and our drinking water. That's the equivalent of about one credit card. The particles are so small that they can even cross the blood-brain barrier and, thus, enter our brain.
Constantly activeThere, they are recognized and eaten by microglia, whose job it is to take up unwanted and foreign particles in their environment. The problem is that when a lot of plastic gets into the brain, the cells may become constantly active leading to a permanent immune response. Hints that this could actually happen in vivo comes from cell culture studies showing that macrophages mount an immune response when treated with nano-sized particles.
Disease driver?In their “NanoGlia” project, they investigate whether nearby nerve cells could be damaged by this — and whether this could play a role in the development of neurodegenerative diseases.
Affecting the embryo?They seek to understand which types of plastic enter the brain and are taken up by the macrophages. Furthermore, they also investigate whether nanoplastics in the bodies of pregnant women can enter the embryo via the placenta — and what consequences this could have.
Recharging batteriesIn addition to the excellent research conditions at the institute, the team also appreciates the high recreational value of the location. The team regularly recharges its batteries for new ideas in the lab during joint activities in and around Bonn. For example, during a hike in the nearby Siebengebirge.
Nanobodies
NanobodiesTools for research — therapies for humans — supported by llamas and alpacas
To generate the nanobodies, they receive help from their animal colleagues.
Photo: UKB, Stabsstelle Kommunikation & Medien
ImmunizationTo produce these nanobodies, animals are immunized with a specific antigen. In response, B cells encoding suitable antibodies expand and secrete the antibodies. The process is comparable to vaccinations in humans and does not harm the animals.
Photo: UKB, Stabsstelle Kommunikation & Medien
From the field to the labA blood sample is then taken from the Alpaca. It contains the B cells that the immune system of the animal has selected in response to the vaccination. In a first step in the lab, these cells are separated from red blood cells by centrifugation.
The workhorseThe team then transcribes the genetic information for nanobodies into DNA, and clones the entire diversity of nanobodies into a plasmid library. As a workhorse in the lab, they use phage display to specifically identify nanobodies that bind to a target of choice.
Photo: Volker Lannert / Uni Bonn
High affinityIn this example, the target of choice is immobilized on an ELISA plate and Florian's lab tests whether the serum contains specific antibodies to it. Nanobodies with high affinity are selected. Once they have these nanobodies the actual work begins ...
MicroscopyTo better understand the immune response, Florian's team visualizes proteins of choice with nanobodies. Nanobodies are either recombinantly produced in bacteria and fluorescently labelled, or expressed in living cells as a fluorescent fusion protein.
Pyroptosis blockedIf they encounter signs of infection or damage, human macrophages assemble inflammasomes and die by pyroptosis, indicated by the influx of a red DNA dye (top). Cells expressing inhibitory nanobodies no longer die by pyroptosis. This allows us to study processes immeately before cell death (bottom).
Videos: Lisa Schiffelers (Schmidt lab)
Fighting the pandemicResearch in the Schmidt lab does not only open up new avenues in understanding our immune response, but has already yielded promising nanobodies with potential use as therapeutic agents. When the COVID-19 pandemic hit the world, the Core Facility Nanobodies and the Schmidt lab took advantage of their expertise in both nanobody generation and virology to develop nanobodies that specifically interfere with SARS-CoV-2 infections.
Neutralizing SARS-CoV-2Early in the pandemic, they immunized an animal with the spike protein of SARS-CoV-2 and managed to develop nanobodies that can specifically neutralize SARS-CoV-2 and its variants by a novel mechanism: Nanobodies prematurely activated the viral fusion machinery and thus render virions non-infectious. The video shows how addition of the nanobodies to cells expressing SARS-CoV-2 spike initiates massive cell-to-cell fusion (a way to macroscopically observe the premature fusion activity).
Videos: Florian Gohr (Schmidt lab)
Team SpiritThe University of Bonn offers a vibrant and collaborative research environment with plenty of space for exchange and joint initiatives. In Bonn, young scientists are seen as an opportunity and are given the space and trust to create their own research niche.
The power of microscopy
The power of microscopyMaking the invisible visble
Increasing threat to human healthThe importance of deciphering Staphylococcus aureus infection mechanisms is relevant because systemic S. aureus infection is one of the most serious and frequent bacteraemias worldwide. A major challenge in treating S. aureus is the increasing resistance against antibiotics. Methicillin-resistant S. aureus (MRSA) was classified by the World Health Organization (WHO) as one of twelve priority pathogens that threaten human health. Understanding how S. aureus escapes the immune response is therefore crucial to control the infection.
Neutrophils do not distribute the bacteriaHow do the bacteria manage to reach other organs? The main theory for a long time was that neutrophils take up the bacteria and act as Trojan Horses that distribute the bacteria over the full body. Jorch and her team's research doesn't confirm this theory. Using intravital imaging they could show that bacteria are not taken up by neutrophils.
Overgrown by bacteriaWhat they could show instead is that some Kupffer cells get overgrown by bacteria and basically spit them out into the surrounding area.
(Video: Isolated Kupffer cells 30 min post-infection. S. aureus (green). Kupffer cells are imaged in brightfield. Video starts at 5h post-infection.)
Selina K. Jorch
Focus on the peritoneal cavityTo determine the destination of bacteria released from the liver, the team performed a systematic assessment of the bacterial load in every organ over time. Surprisingly, the compartment with the most obvious increase in bacterial load was the peritoneal cavity.
Infection of the kidneysThis situation changes at about 24 hours after infection. Then the number of bacteria in the kidneys increases rapidly. The team investigated how the bacteria arrive in the kidneys and why they aren't taken up by neutrophils.
Infection via peritoneal cavityUsing 2-photon microscopy the team revealed that the bacteria are attached to the surface and not below the capsule. This observation suggests that bacteria were infecting the kidney from the outer surface inward via the peritoneal cavity. But why are the bacteria still not taken up by Neutrophils?
(Animation: 3D reconstruction of S. aureus on the kidney capsule 48 hours post-infection. Purple: Collagen (SHG), Green: S. aureus. Grey: Vasculature. Brown: Tubular autofluorescence)
Selina K. Jorch
Haven for bacteriaThe team's data show that S. aureus in the peritoneal cavity immediately infected GATA-binding factor 6–positive (GATA6+) peritoneal cavity macrophages. These macrophages provide a haven for the bacteria to grow inside, thereby delaying the neutrophilic response in the peritoneum by 48 hours and allowing dissemination to various peritoneal and retroperitoneal organs including the kidneys. In mice deficient in GATA6+ peritoneal macrophages, neutrophils infiltrated more robustly and reduced S. aureus dissemination.
Support and collaborationAn important factor for reaching these goals is the collaborative and supportive research space that the University of Bonn provides. Apart from having access to state-of-the-art microscopy techniques for their investigations Selina Jorch and her team appreciate an environment where young scientists are seen as an opportunity.
Family-friendlyAnother benefit when working in the ImmunoSensation excellence cluster is their support for families. The cluster helps to find daycare and offers a resting room for parents and their children at the university.
ImmunoSensation
Join the TeamWe offer perspectives
We are always interested to hear from motivated individuals. We support early careers. Feel free to get in touch:
ImmunoSensation2 Cluster of Excellence
Cluster Coordination Office
University Hospital Bonn
Venusberg - Campus 1
D-53127 Bonn
Phone. +49 228 287-51288
immunosensation(at)uni-bonn.dewww.immunosensation.de
This multimedia project is supported by the Henriette Herz Award of the Alexander von Humboldt Foundation.

Introduction
Introduction
 Beyond the boundaries
Beyond the boundaries
 Mighty macrophages
Mighty macrophages
 Elvira Mass – Developmental biologist
Elvira Mass – Developmental biologist
 Birth of microglia
Birth of microglia
 Synaptic pruning
Synaptic pruning
 Cleaning up the brain
Cleaning up the brain
 Plastic in our brain
Plastic in our brain
 Constantly active
Constantly active
 Elvira Mass – Developmental biologist
Elvira Mass – Developmental biologist
 Disease driver?
Disease driver?
 Affecting the embryo?
Affecting the embryo?
 Elvira Mass – Developmental biologist
Elvira Mass – Developmental biologist
 Recharging batteries
Recharging batteries
 Elvira Mass – Developmental biologist
Elvira Mass – Developmental biologist
 Nanobodies
Nanobodies
 Florian I. Schmidt – Immunologist
Florian I. Schmidt – Immunologist
 Immunization
Immunization
 From the field to the lab
From the field to the lab
The workhorse
The workhorse
 High affinity
High affinity
 Microscopy
Microscopy
 Florian I. Schmidt – Immunologist
Florian I. Schmidt – Immunologist
 Pyroptosis blocked
Pyroptosis blocked
 Fighting the pandemic
Fighting the pandemic
 Neutralizing SARS-CoV-2
Neutralizing SARS-CoV-2
 Florian I. Schmidt – Immunologist
Florian I. Schmidt – Immunologist
 Team Spirit
Team Spirit
 Florian I. Schmidt – Immunologist
Florian I. Schmidt – Immunologist
 The power of microscopy
The power of microscopy
 Increasing threat to human health
Increasing threat to human health
 Selina K. Jorch – Immunologist
Selina K. Jorch – Immunologist
 Neutrophils do not distribute the bacteria
Neutrophils do not distribute the bacteria
 Overgrown by bacteria
Overgrown by bacteria
 Focus on the peritoneal cavity
Focus on the peritoneal cavity
 Infection of the kidneys
Infection of the kidneys
 Selina K. Jorch – Immunologist
Selina K. Jorch – Immunologist
 Infection via peritoneal cavity
Infection via peritoneal cavity
 Haven for bacteria
Haven for bacteria
 Selina K. Jorch – Immunologist
Selina K. Jorch – Immunologist
 Support and collaboration
Support and collaboration
 Family-friendly
Family-friendly
 Selina K. Jorch – Immunologist
Selina K. Jorch – Immunologist
 Join the Team
Join the Team
 Introduction
Introduction